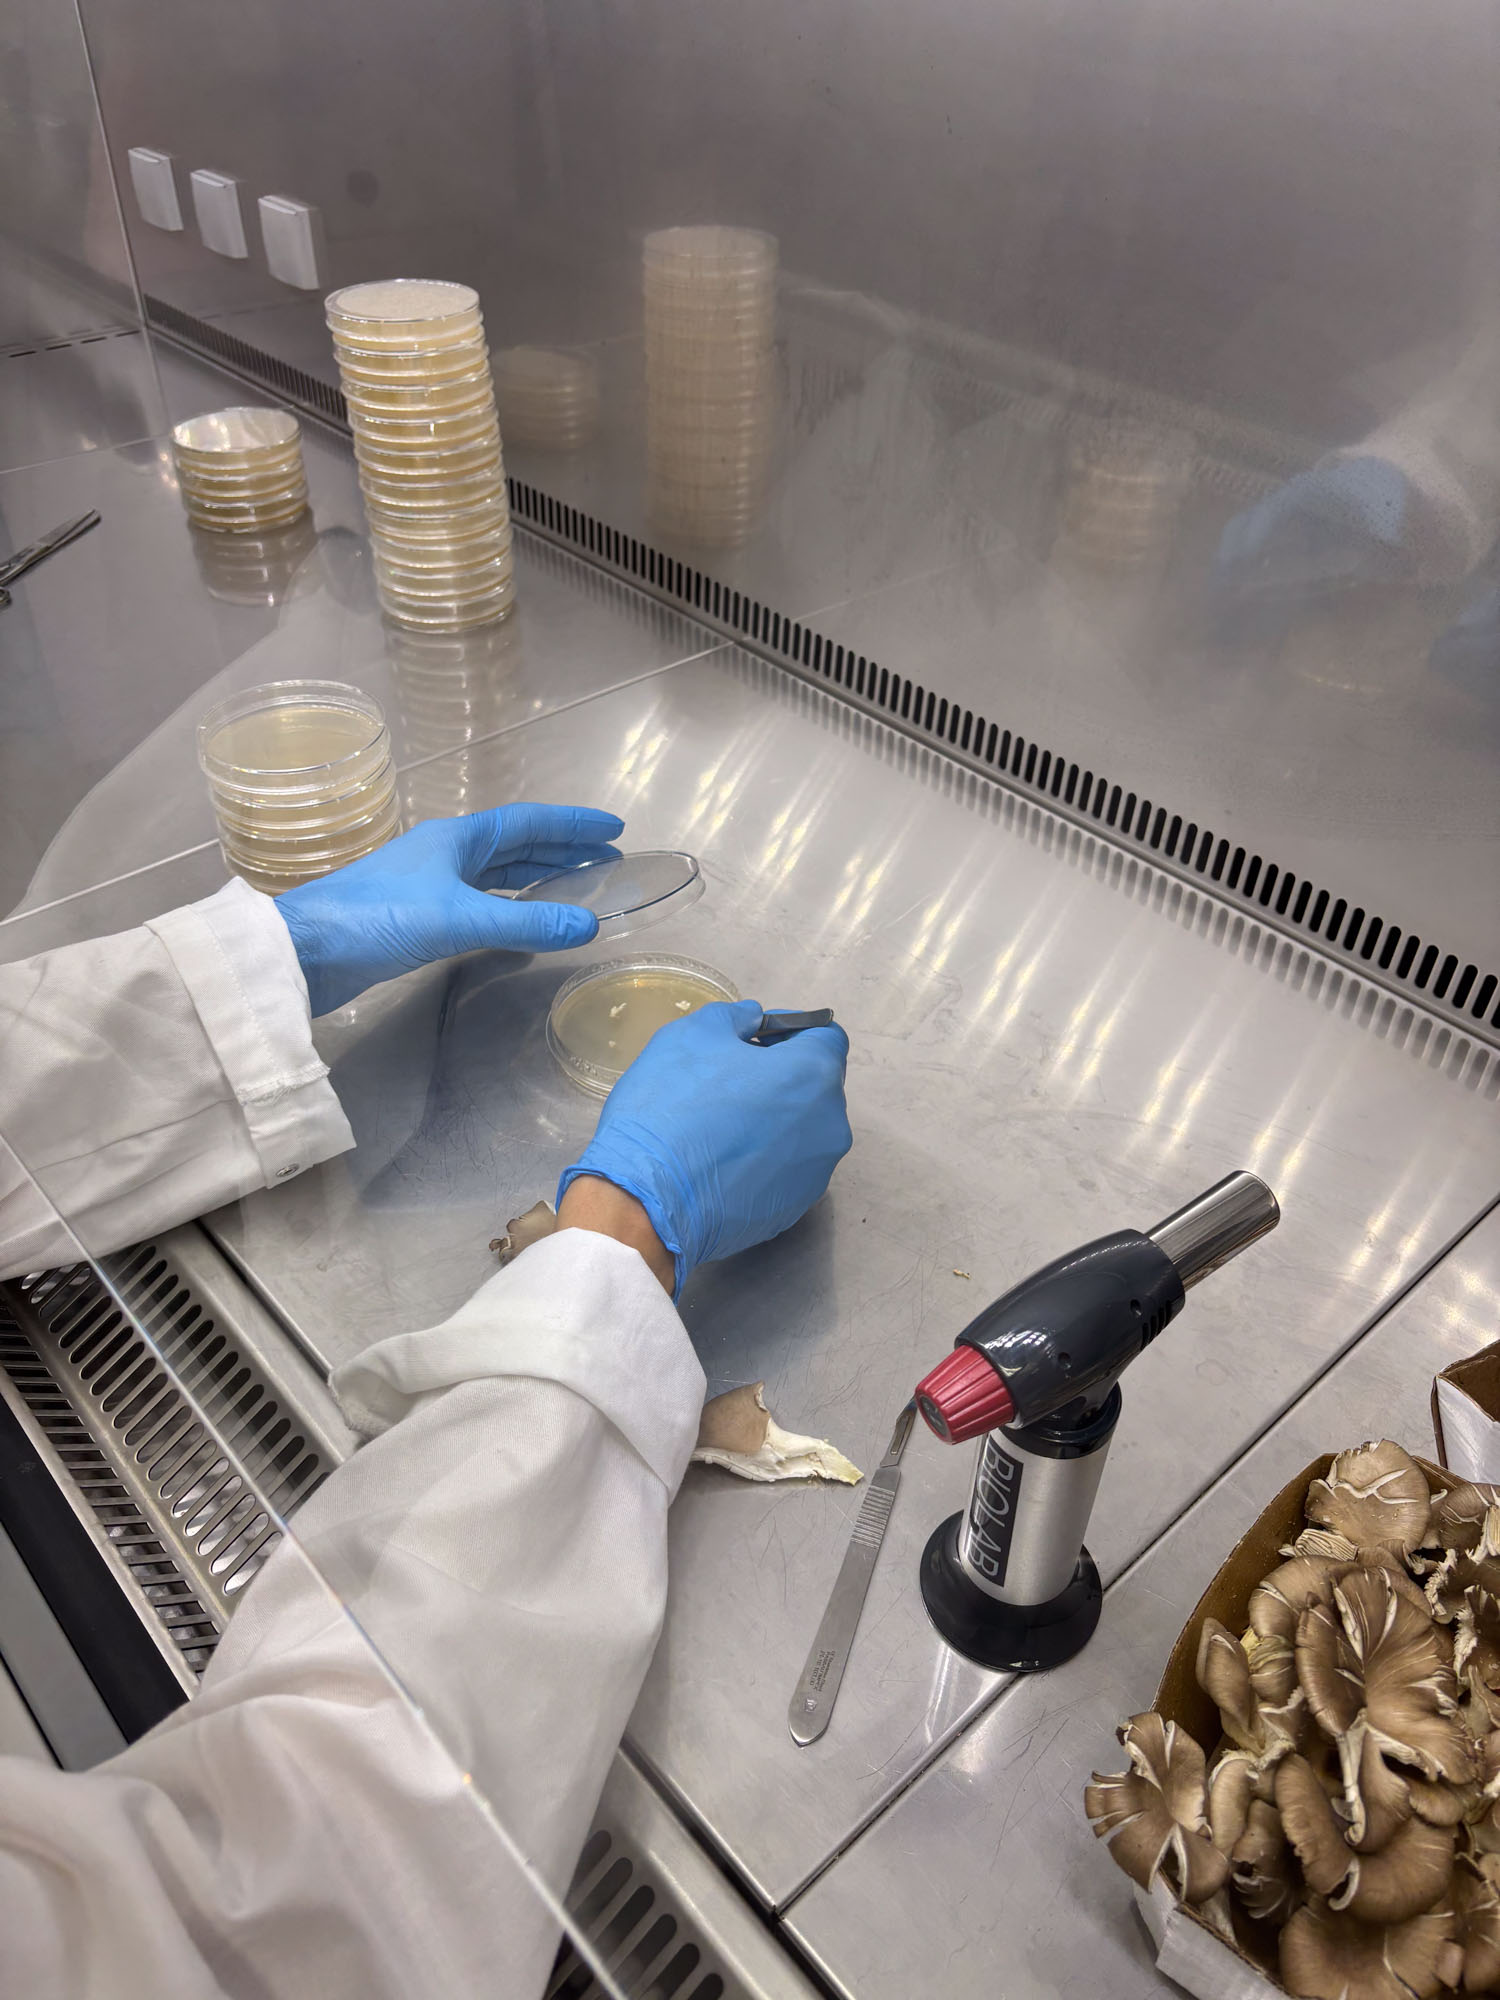

Erste Testserien mit Pizzaschachteln mit Ölresten wurden mit verschiedenen Verhältnissen mit Reihi und Hanf kombiniert. Das Öl hemmte das Wachstum des Myzels nicht. Bilder von links nach rechts: 1. Nach 1 Tag, 2. Nach 7 Tagen, 3. Nach 10 Tagen
© Nadine Schütz